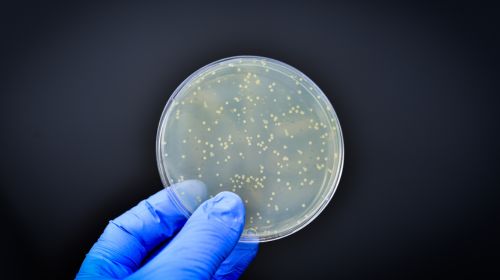

Abrir en el navegador
Abrir en el navegador
|

|

|
Noticias destacadas
|

|
Qualipharma y PTM Consulting sellan una colaboración estratégica para transformar la gestión de procesos farmacéuticos
La industria farmacéutica afronta retos cada vez más complejos: normativas estrictas, plazos exigentes y presión...
Continuar leyendo
|
|

|

|
Farmaforum 2025 a punto de agotar sus stands en IFEMA Madrid
El principal foro de la industria farmacéutica, biofarmacéutica, cosmética y tecnologías afines en España...
Continuar leyendo
|
|

|
AseBio Te cuenta
|

|
El proyecto ShapingBio, con participación de AseBio, propone a la CE una hoja de ruta para una bioeconomía europea competitiva
La bioeconomía se consolida como un pilar estratégico para la transformación verde y la autonomía...
Continuar leyendo
|
|

|
Actualidad de Farmabiotec
|

|
La directora de la AEMPS visita la planta de Viralgen en San Sebastián, referente europeo en terapias avanzadas
La directora general de la Agencia Española de Medicamentos y Productos Sanitarios (AEMPS), María Jesús Lamas,...
Continuar leyendo
|
|

|

|
Un estudio del Instituto de Neurociencias descubre el vínculo entre una mutación genética del autismo y la alteración de la conducta social
Un estudio internacional liderado por el Instituto de Neurociencias (IN), centro mixto del Consejo Superior de Investigaciones Científicas...
Continuar leyendo
|
|

|
Eli Lilly presenta resultados positivos de supervivencia global con abemaciclib en cáncer de mama temprano
Eli Lilly and Company ha presentado resultados preliminares positivos del análisis de supervivencia global (SG) del estudio fase...
Continuar leyendo
|
|

|

|
Los microforámenes craneales podrían ser clave en la inmunidad, la regulación térmica y la evolución humana
Un estudio pionero llevado a cabo por Emiliano Bruner, investigador del Museo Nacional de Ciencias Naturales-CSIC, ha descrito por primera...
Continuar leyendo
|
|

|
Novartis logra resultados positivos en fase III con ianalumab para la enfermedad de Sjögren
Novartis ha anunciado resultados positivos de los estudios de Fase III NEPTUNUS-1 y NEPTUNUS-2 que evalúan ianalumab (VAY736) en...
Continuar leyendo
|
|

|

|
Entrevista a Alfonso García Cañamaque, CEO de Leon Research y ponente en Farmaforum 2025: “El paciente informado cambia las reglas del reclutamiento en ensayos clínicos”
El reclutamiento de pacientes sigue siendo uno de los mayores retos de la investigación clínica. En esta entrevista, Alfonso...
Continuar leyendo
|
|

|
Theriva Biologics avanza hacia Fase 3 con VCN-01 tras resultados positivos en cáncer de páncreas
Theriva Biologics ha anunciado sus resultados financieros del segundo trimestre de 2025 y ha compartido actualizaciones clave sobre su pipeline...
Continuar leyendo
|
|

|

|
Oryzon obtiene la aprobación de la EMA para iniciar el ensayo RESTORE con iadademstat en anemia de células falciformes
Oryzon Genomics S.A. ha anunciado que la Agencia Europea de Medicamentos (EMA) ha aprobado su Solicitud de Autorización de Ensayo...
Continuar leyendo
|
|

|
Identifican una ventana crítica postnatal que condiciona la neurogénesis adulta: clave el gen Sox5
Una investigación del Centro de Neurociencias Cajal-CSIC (Madrid) ha descubierto un nuevo mecanismo que controla la generación...
Continuar leyendo
|
|

|

|
Investigadores del IBFG y la Universidad de Salamanca lideran un avance clave contra la resistencia fúngica
La resistencia a los antifúngicos, recientemente incorporada a la lista de prioridades sanitarias de la OMS, se ha consolidado como...
Continuar leyendo
|
|

|
Ejercicio moderado y microbiota intestinal: claves para mejorar la memoria y la neurogénesis, según el CSIC
Un trabajo del Centro de Neurociencias Cajal (CNC) del CSIC, publicado en la revista eBioMedicine del grupo The Lancet, muestra que los...
Continuar leyendo
|
|

|

|
CSIC y BSC desarrollan una técnica para reprogramar bacterias sin introducir genes externos
Equipos liderados por el Consejo Superior de Investigaciones Científicas (CSIC) y el Barcelona Supercomputing Center – Centro...
Continuar leyendo
|
|

|
La IA generativa impulsa el desarrollo de nuevos tratamientos contra enfermedades cutáneas complejas
La biofarmacéutica Almirall y la compañía estadounidense Absci Corporation, especializada en el uso...
Continuar leyendo
|
|

|

|
El estudio fase III, autorizado por la AEMPS, evaluará la eficacia de MBK-01, una innovadora formulación oral desarrollada por la biotecnológica vasca
La biotecnológica Mikrobiomik ha comenzado el reclutamiento de pacientes para LiverGut, un ensayo clínico fase III, aleatorizado,...
Continuar leyendo
|
|

|
El metabolito ImP, producido por la microbiota intestinal, se comporta como marcador temprano y agente causal de la enfermedad cardiovascular más común
Un estudio liderado por el Centro Nacional de Investigaciones Cardiovasculares (CNIC) y publicado en la revista Nature ha identificado un...
Continuar leyendo
|
|

|

|
Más de 4.000 votos se han emitido para reconocer a las mejores empresas del sector en Farmaforum 2025
Más de 4.000 votos se han emitido para elegir a las empresas más destacadas del año en las principales áreas...
Continuar leyendo
|
|

|
Una investigación del CSIC revela cómo el deterioro del sistema inmune y la disbiosis intestinal están conectados con la multimorbilidad asociada a la edad
La pérdida de funcionalidad de los linfocitos T CD4 contribuye al deterioro de la barrera intestinal, desencadenando inflamación...
Continuar leyendo
|
|

|
|
El 70 % de los genes de resistencia a antibióticos están presentes en la cadena alimentaria
Una investigación internacional liderada por el proyecto europeo MASTER ha detectado que más del 70 % de los genes bacterianos...
Continuar leyendo
|
|

|
Un test de sangre desarrollado en el CNIO permite detectar cáncer en fases tempranas con alta precisión
Un equipo del Centro Nacional de Investigaciones Oncológicas (CNIO), liderado por Gonçalo Bernardes, ha desarrollado una nueva...
Continuar leyendo
|
|

|

|
Tirzepatida demuestra eficacia comparable a dulaglutida en eventos cardiovasculares y mejora múltiples parámetros clínicos en el estudio SURPASS-CVOT
Eli Lilly and Company ha anunciado los resultados principales del estudio SURPASS-CVOT, un ensayo clínico fase 3 de resultados cardiovasculares...
Continuar leyendo
|
|

|
Profesionales de compañías líderes promueven el PDA Spain Chapter como nuevo espacio de conocimiento técnico y científico
Un grupo de profesionales de referencia de la industria biofarmacéutica española ha iniciado el proceso de constitución...
Continuar leyendo
|
|

|

|
Investigadores del CSIC participan en el desarrollo de la escala de riesgo genético más completa para la detección precoz del alzhéimer
Un equipo internacional con participación de investigadores del Consejo Superior de Investigaciones Científicas (CSIC) ha...
Continuar leyendo
|
|

|
El CSIC presenta una innovadora plataforma de diagnóstico molecular que detecta ARN viral sin necesidad de tratamiento previo de la muestra
Un equipo del Instituto de Microelectrónica de Barcelona del CSIC (IMB-CNM-CSIC) ha desarrollado una nueva plataforma portátil...
Continuar leyendo
|
|

|

|
El grupo Zendal anuncia el jurado de los VI International Zendal Awards, con 65.000 euros en premios para proyectos de salud humana y animal
El grupo biofarmacéutico ZENDAL ha hecho pública la composición del comité científico de la sexta edición...
Continuar leyendo
|
|

|
Artículos
|

|
Nitrógeno en las industrias farmacéutica y química
El nitrógeno es un elemento fundamental en las industrias farmacéutica y química debido a su inercia, disponibilidad y capacidad para intervenir...
Artículo completo
|
|

|
Credibilidad de la IA farmacéutica: claves del borrador de la FDA
La FDA pone la credibilidad como uno de los ejes centrales para la aceptación de la inteligencia artificial (IA) en la industria farmacéutica....
Artículo completo
|
|

|
Diagnóstico por imagen ayudado por IA: marco regulatorio y evolución en el desarrollo
La evolución de la medicina necesariamente irá de la mano de la biotecnología, la bioinformática, y los avances computacionales....
Artículo completo
|
|
Eventos recomendados
|

|
Farmaforum 2025
17/09/2025
IFEMA, Pabellón 9, Madrid (España)
Más información
|
|

|
BIOSPAIN 2025
07/10/2025
Fira de Barcelona - Gran Vía, Barcelona (España)
Más información
|
|

|
Medicalforum 2026
21/04/2026
Hotel Catalonia Plaza, Barcelona (España)
Más información
|
|
Empresas premium
|
|
|
|
Este mensaje y sus adjuntos contienen información confidencial y reservada dirigida exclusivamente a su destinatario. Si ha recibido este mensaje por error, se ruega lo notifique inmediatamente por esta misma vía y borre el mensaje de su sistema. Nótese que el correo electrónico vía Internet no permite asegurar ni la confidencialidad de los mensajes que se transmiten ni la correcta recepción de los mismos. Los datos derivados de su correspondencia se incluyen en un fichero de titularidad de OMNIMEDIA, S.L. cuya finalidad exclusiva es gestionar las comunicaciones de la empresa entendiéndose que usted consiente el tratamiento de los mismos con dicha finalidad al mantener tal correspondencia. El ejercicio de sus derechos de acceso, rectificación, cancelación u oposición puede realizarlo dirigiéndose por escrito a la dirección C/ Pollensa, 2, Edif. Artemisa of. 12 de LA ROZAS (28290 - MADRID) adjuntando una fotocopia de su NIF o documento identificativo.
Este mensaje se ha enviado a {{ campaign.sender.email }} que está registrado dentro del listado de suscriptores de nuestra revista. Si no desea recibir más información y darse de baja de nuestros boletines click aquí
|



































